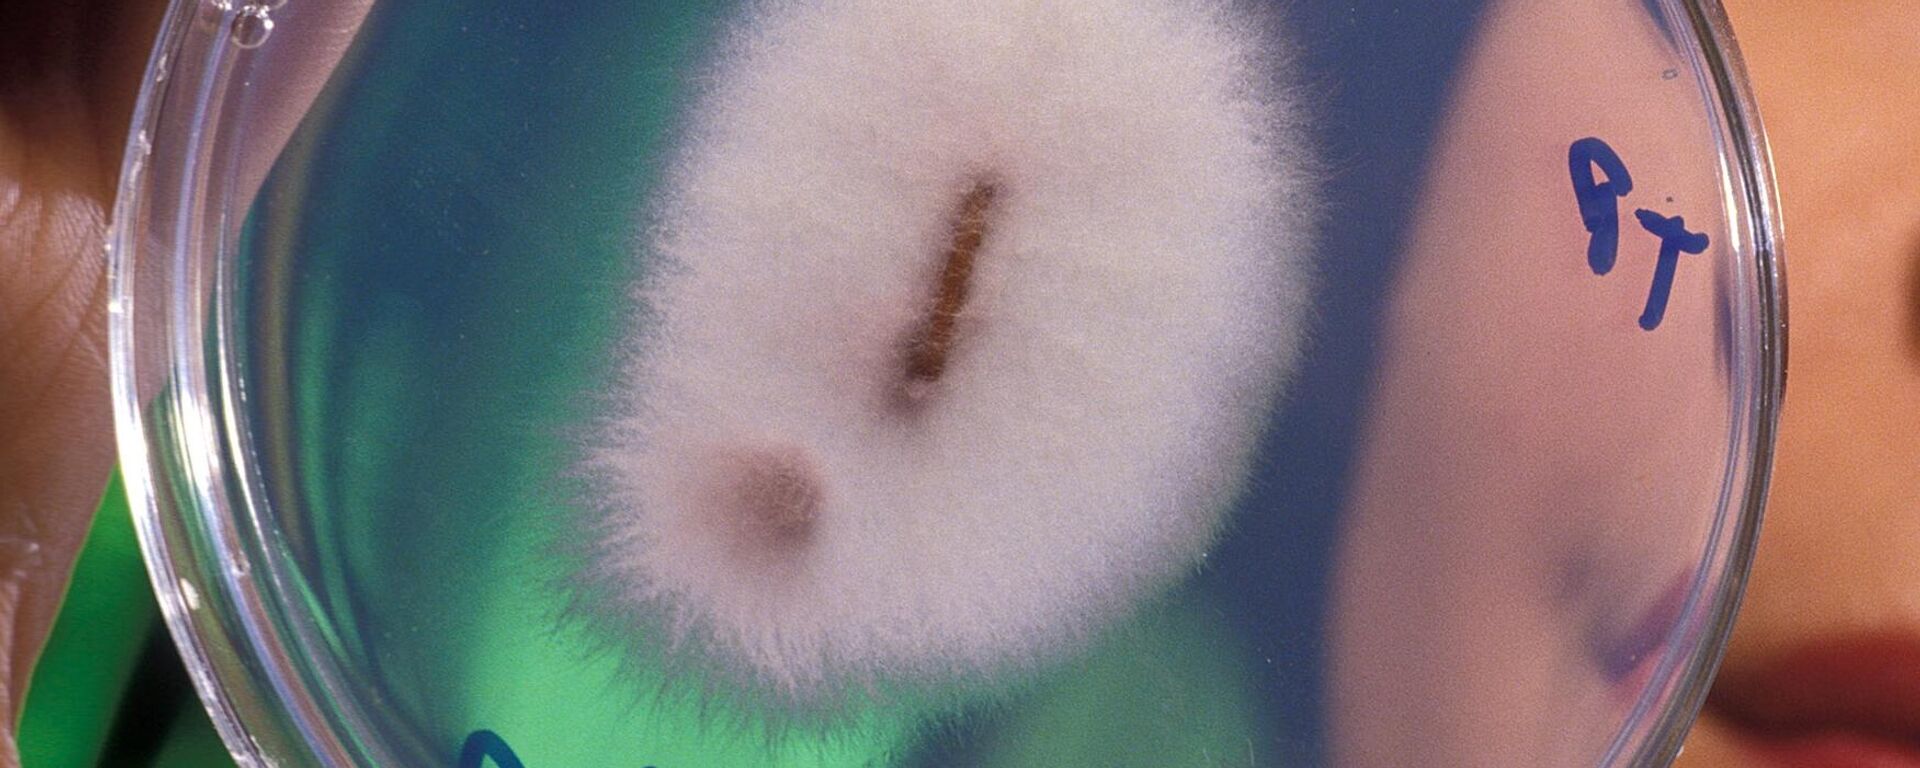
Fusarium oxysporum - Sputnik Mundo, 1920, 29.04.2021

https://noticiaslatam.lat/20210519/prefectos-de-5-provincias-de-ecuador-buscan-evitar-el-ingreso-de-agresivo-hongo-tropical-1112323634.html
Prefectos de 5 provincias de Ecuador buscan evitar el ingreso de agresivo hongo tropical
Prefectos de 5 provincias de Ecuador buscan evitar el ingreso de agresivo hongo tropical
Sputnik Mundo
QUITO (Spuntnik) — Prefectos de cinco provincias productoras de banano en Ecuador se reunieron en la ciudad de Huaquillas (sur), en la provincia de El Oro... 19.05.2021, Sputnik Mundo
2021-05-19T00:54+0000
2021-05-19T00:54+0000
2021-05-19T00:55+0000
américa latina
ecuador
hongos
https://cdn.img.noticiaslatam.lat/img/103604/76/1036047692_0:177:2929:1824_1920x0_80_0_0_e6212cbcf5acb6e62d2ffaf128d06413.jpg
Los prefectos de El Oro (suroeste), Guayas (oeste), Los Ríos (oeste), Santa Elena (oeste) y Manabí (oeste) se reunieron para compartir estrategias y alinear sus mensajes y de esta forma concienciar a la ciudadanía de la amenaza del Fusarium, considerada una de las 10 enfermedades más letales de la agricultura, publicó el portal digital Primicias.Además, se habilitó un arco de desinfección en el Centro Binacional de Atención Fronteriza (Cebaf), en Huaquillas, para fumigar a los vehículos que arriban desde Perú.El agresivo hongo apareció en la década de los 90 en Taiwán y en 12 años afectó unas 1.200 hectáreas para luego extenderse a los países del sudeste asiático y África y, finalmente, llegar a Latinoamérica.Según expertos, los efectos del hongo son tan letales como la fiebre aftosa en los bovinos, la influenza aviar H5N1 en las aves, la peste porcina en los cerdos o la viruela en los humanos.El hongo se descubrió en abril en Perú, en el departamento de Piura, lo cual hizo reforzar las acciones preventivas en Ecuador.El prefecto de Los Ríos, Johnny Terán, dijo que durante un encuentro celebrado días antes en la ciudad de Guayaquil (oeste) con sus pares acordaron una hoja de ruta de prevención con el objetivo de proteger la productividad de las provincias bananeras, a través de capacitaciones de bioseguridad a pequeños y medianos productores.Según datos oficiales, la industria bananera involucra a dos millones de personas de manera directa e indirecta y representa el 17% del Producto Interno Bruto (PIB) del país suramericano.Ecuador es uno de los mayores productores y el principal exportador de banano en el mundo y su fruta es mayormente apetecida en grandes mercados de Rusia, Europa, y Estados Unidos, entre otros.Desde 2018, Ecuador refuerza planes, protocolos y normativas para evitar el ingreso del hongo a sus plantaciones bananeras; al momento existen al menos 11 resoluciones técnicas y acuerdos ministeriales que, desde el punto de vista normativo, a través de análisis de riesgo, buscan ese objetivo por diversas vías.
https://noticiaslatam.lat/20210429/1111748036.html
https://noticiaslatam.lat/20210426/1111601494.html
ecuador
Sputnik Mundo
contacto@sputniknews.com
+74956456601
MIA „Rossiya Segodnya“
2021
Sputnik Mundo
contacto@sputniknews.com
+74956456601
MIA „Rossiya Segodnya“
Noticias
es_ES
Sputnik Mundo
contacto@sputniknews.com
+74956456601
MIA „Rossiya Segodnya“
https://cdn.img.noticiaslatam.lat/img/103604/76/1036047692_130:0:2797:2000_1920x0_80_0_0_409a205ef028e702fe5d619bab324ecb.jpgSputnik Mundo
contacto@sputniknews.com
+74956456601
MIA „Rossiya Segodnya“
ecuador, hongos
Prefectos de 5 provincias de Ecuador buscan evitar el ingreso de agresivo hongo tropical
00:54 GMT 19.05.2021 (actualizado: 00:55 GMT 19.05.2021) QUITO (Spuntnik) — Prefectos de cinco provincias productoras de banano en Ecuador se reunieron en la ciudad de Huaquillas (sur), en la provincia de El Oro, fronteriza con Perú, con el objetivo de unir esfuerzos en la estrategia para impedir el ingreso del hongo Fusarium Raza 4 Tropical (Foc - R4T), informó la prensa local.
Los prefectos de El Oro (suroeste), Guayas (oeste), Los Ríos (oeste), Santa Elena (oeste) y Manabí (oeste) se reunieron para compartir estrategias y alinear sus mensajes y de esta forma concienciar a la ciudadanía de la amenaza del Fusarium, considerada una de las 10 enfermedades más letales de la agricultura, publicó el portal digital Primicias.
Además, se habilitó un arco de desinfección en el Centro Binacional de Atención Fronteriza (Cebaf), en Huaquillas, para fumigar a los vehículos que arriban desde Perú.
29 de abril 2021, 22:13 GMT
El agresivo hongo apareció en la década de los 90 en Taiwán y en 12 años afectó unas 1.200 hectáreas para luego extenderse a los países del sudeste asiático y África y, finalmente, llegar a Latinoamérica.
Según expertos, los efectos del hongo son tan letales como la fiebre aftosa en los bovinos, la influenza aviar H5N1 en las aves, la peste porcina en los cerdos o la viruela en los humanos.
El hongo se descubrió en abril en Perú, en el departamento de Piura, lo cual hizo reforzar las acciones preventivas en Ecuador.
El prefecto de Los Ríos, Johnny Terán, dijo que durante un encuentro celebrado días antes en la ciudad de Guayaquil (oeste) con sus pares acordaron una hoja de ruta de prevención con el objetivo de proteger la productividad de las provincias bananeras, a través de capacitaciones de bioseguridad a pequeños y medianos productores.

26 de abril 2021, 21:50 GMT
Según datos oficiales, la industria bananera involucra a dos millones de personas de manera directa e indirecta y representa el 17% del Producto Interno Bruto (PIB) del país suramericano.
Ecuador es uno de los mayores productores y el principal exportador de banano en el mundo y su fruta es mayormente apetecida en grandes mercados de Rusia, Europa, y Estados Unidos, entre otros.
Desde 2018, Ecuador refuerza planes, protocolos y normativas para evitar el ingreso del hongo a sus plantaciones bananeras; al momento existen al menos 11 resoluciones técnicas y acuerdos ministeriales que, desde el punto de vista normativo, a través de análisis de riesgo, buscan ese objetivo por diversas vías.